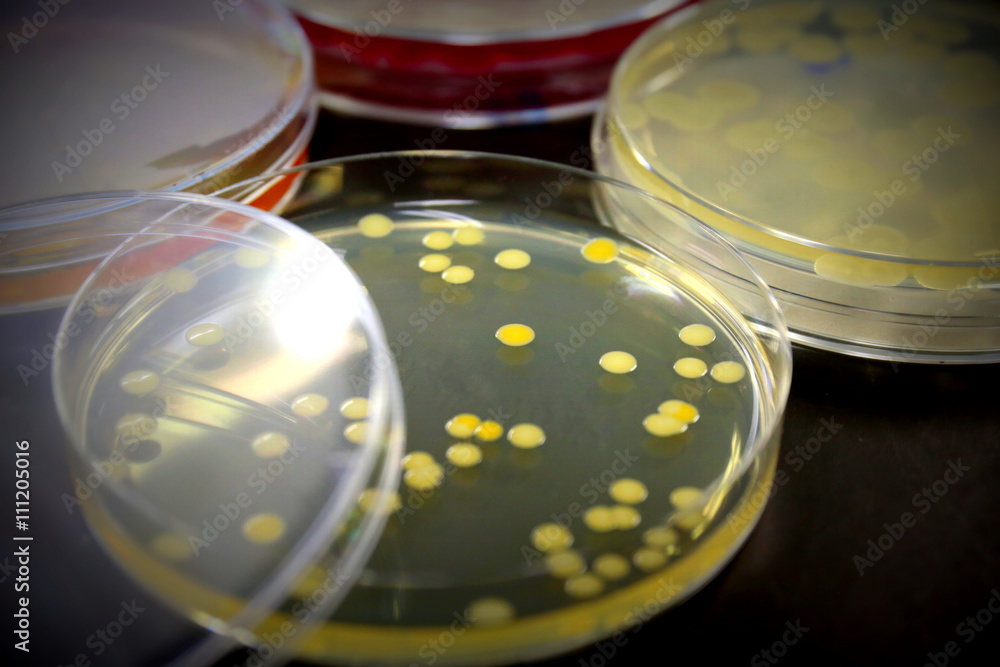

事業名
大腸菌/枯草菌のテーラーメイド多重遺伝子破壊変異体作成
チーム
微生物開発チーム
受託業務の内容
大腸菌、枯草菌の両菌株では遺伝子変異の作成に必要な遺伝学的技術が確立されています。また1遺伝子破壊リソースが既に整備され、これを基にさらに二重、三重といった多重遺伝子破壊株の作成が可能です。
本事業では、利用者が必要とする組み合わせの多重変異体の作成を行います。また、作成した多重変異体の生育速度、細胞形態など基本的な増殖の情報測定も要望により実施します。特に実験進化や合成生物学など理論やゲノム情報を主体とする研究者が、自らのモデルを実証研究するにあたって必要なリソースの作成、そしてその表現形解析を支援します。
基本費用(大学・公的研究機関向け価格を掲載、企業向け価格は要相談)
一遺伝子あたり46,600円(税込)
